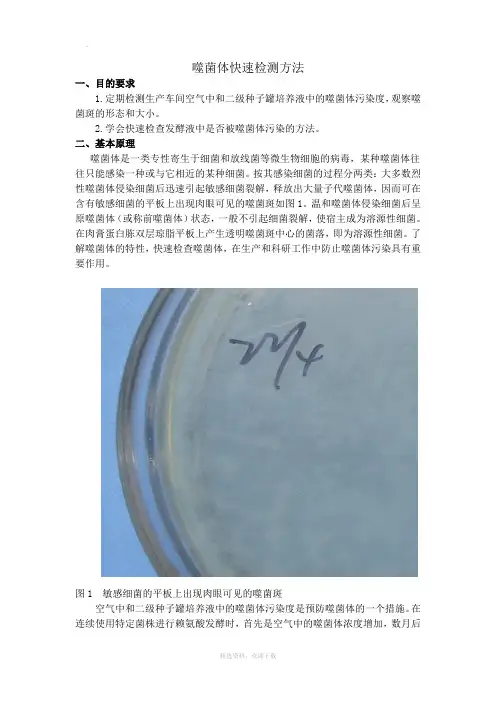

细菌噬菌体应该如何检测
- 格式:doc
- 大小:219.00 KB
- 文档页数:3
噬菌体快速检测方法一、目的要求1.定期检测生产车间空气中和二级种子罐培养液中的噬菌体污染度,观察噬菌斑的形态和大小。
2.学会快速检查发酵液中是否被噬菌体污染的方法。
二、基本原理噬菌体是一类专性寄生于细菌和放线菌等微生物细胞的病毒,某种噬菌体往往只能感染一种或与它相近的某种细菌。
按其感染细菌的过程分两类:大多数烈性噬菌体侵染细菌后迅速引起敏感细菌裂解,释放出大量子代噬菌体,因而可在含有敏感细菌的平板上出现肉眼可见的噬菌斑如图1。
温和噬菌体侵染细菌后呈原噬菌体(或称前噬菌体)状态,一般不引起细菌裂解,使宿主成为溶源性细菌。
在肉膏蛋白胨双层琼脂平板上产生透明噬菌斑中心的菌落,即为溶源性细菌。
了解噬菌体的特性,快速检查噬菌体,在生产和科研工作中防止噬菌体污染具有重要作用。
图1 敏感细菌的平板上出现肉眼可见的噬菌斑空气中和二级种子罐培养液中的噬菌体污染度是预防噬菌体的一个措施。
在连续使用特定菌株进行赖氨酸发酵时,首先是空气中的噬菌体浓度增加,数月后种子罐的噬菌体浓度也急剧增加,随之主发酵罐发酵液中的噬菌体检出浓度也就增加;当空气中的噬菌体浓度上升到每个平板达10~20PFU/ml(噬菌斑生成单位)时,二级种子罐的噬菌体浓度为40~50 PFU/ml;之后迅速增加,达到102 PFU/ml的程度,终于在主发酵罐发生溶菌。
经常检测赖氨酸分厂环境中,特别是空气中与种子罐二级种子液中的噬菌体数,就能知道环境的噬菌体污染程度,也就能预知主发酵罐中会不会发生噬菌体的污染。
噬菌体是病毒的一种,是一种极其微小的生物,体积是细菌的1/1000左右,它可以通过细菌过滤器,只有在电子显微镜下才能看到。
噬菌体具有非常专一的寄生性,只能在特异性寄主细胞中增殖。
由于噬菌体缺乏独立代谢的酶体系,不能脱离寄生而自行生长繁殖,因而噬菌体的繁殖必须依存于寄生菌的繁殖,只能在活的正在繁殖阶段的细胞中进行增殖。
在死的、衰老的、处于休眠状态的细胞中以及在代谢产物或培养基上都无法繁殖。


噬菌体滴度测定方法
噬菌体滴度测定是一种用于测定噬菌体(一种寄生于细菌的病毒)浓度的方法。
这种方法通常用于实验室中对噬菌体的研究和生产中的质量控制。
噬菌体滴度测定可以通过以下步骤来进行:
1. 制备宿主细菌,首先,需要培养并生长宿主细菌,通常是大肠杆菌等细菌。
这些细菌将被用作噬菌体的寄主。
2. 制备稀释系列,将噬菌体样品进行一系列的稀释,通常是1:10的稀释系列,以便在测定时得到合适的滴度范围。
3. 混合噬菌体和宿主细菌,将每种稀释倍数的噬菌体样品与宿主细菌混合,并在琼脂平板上均匀涂布。
4. 孵育,将含有噬菌体和宿主细菌的琼脂平板在适当的温度下孵育一段时间,通常是在37摄氏度下孵育。
5. 计数形成的克隆,在孵育后,观察并计数每个琼脂平板上形成的克隆(也就是细菌克隆)。
根据稀释倍数和克隆的数量,可以计算出噬菌体的滴度。
噬菌体滴度测定的结果通常以噬菌体的孔径形成单位(PFU)表示,这是一种衡量噬菌体浓度的常用单位。
这种方法对于确定噬菌体溶液的浓度以及在实验室中进行噬菌体相关实验和研究中都具有重要的意义。
除了上述步骤外,还有一些改进的噬菌体滴度测定方法,如双层琼脂平板法和流式细胞术等,可以根据具体实验需求选择合适的方法进行测定。
总的来说,噬菌体滴度测定方法是一种重要的实验技术,对于噬菌体研究和应用具有重要意义。

噬菌体的鉴定方法噬菌体是一种有特定的结构和功能的细菌,它可以充当细菌与宿主,或者细菌和其他微生物之间的中介。
噬菌体的一个主要功能是摄取其它微生物,因此它可以在各种环境中发挥重要作用。
噬菌体通常有两种主要类型,即细胞外噬菌体和细胞内噬菌体。
为了鉴定噬菌体,它们必须具有一套确切的标志物和特性。
一些噬菌体的测定方法可用于鉴定噬菌体,以识别出特定的微生物,确定它们的特征,及其在不同环境中的作用。
一般而言,噬菌体的鉴定首先需要采集样本,然后进行形态、培养特性和生化特性的分析,并根据分析结果进行鉴定。
1、形态特征:这是鉴定噬菌体最常见的方法,此方法通过测量和描述宏观上的形态特点,如细菌的大小、形状和生长形态。
此外,利用电镜也可以观察噬菌体的微观特征,如细菌质膜、细胞壁和质质组成。
2、培养特性:噬菌体的鉴定需要在生化培养基上进行培养,这样可以检测出噬菌体的生长特性,如生长温度、pH和盐度等。
在培养中,向培养基中添加特定的营养物质可以试验由噬菌体产生的特定代谢物作为其识别者。
3、生物学特性:在这一方面,噬菌体可能具有多种独特的生物学特性,如表面多糖结合区,免疫原性,抗药性和对抗识别等。
采用这些特征可以进一步鉴定噬菌体,并将其与其他病原微生物区别开来。
4、分子生物学:这是噬菌体鉴定最精确的方法,可以利用核酸测序(如16S rRNA基因测序和变异性Molecular Markers),或者利用蛋白印迹(如Essential proteins, Non-Essential proteins, Peripheral proteins)回应和不同的子类群的分布等方法确定噬菌体的分子标签。
总而言之,噬菌体的鉴定包括了多个步骤,如采集样本、形态特征、培养特性和生物学特性、分子生物学等,都是噬菌体鉴定的重要依据。
结合不同的分析方法,才能有效地识别噬菌体,评估其在不同环境中的作用。

噬菌体的检测双层琼脂平板法测定噬菌体操作:器材以及药品:1.器材:试管及试管塞(已灭菌)、移液枪(200ul以及5ml)以及相应的无菌枪头、90mm 平板(已灭菌)、250ml三角瓶、酒精灯、琼脂粉、分离提纯的噬菌体液以及敏感菌(已经活化好的)。
方法及步骤:1.配制培养基:LB液体培养基(1000ml水:10g蛋白胨:5g酵母粉:5g氯化钠)、1.5%的固体培养基、0.7%的半固体培养基;2.倒平板:将1.5%的固体培养基熔化,每个平板倒10-15ml的1.5%固体培养基,然后静置至平板上没有水珠为好,平板数根据实际需要而定;3.分装0.7%的半固体培养基:将0.7%的半固体培养基加热熔化,然后用5ml的移液枪向每个试管(已灭菌)加入5ml的半固体培养基;试管的数量和上一步平板数是相同的。
如果试管很多,防止培养基凝固,可将已分装好的试管放入水浴温度为55℃左右的水浴锅中保温;4.等到试管中培养基温度降至45 ℃-50 ℃之间(不烫手)时,迅速向试管中加入100ul 敏感菌和100ul的噬菌体液(噬菌体浓度要适当,这样才能看到明显的噬菌斑),摇匀;5.将摇匀好的该培养基迅速倒入之前已倒有1.5%固体培养基平板中,晃动平板,使其铺满平板,静置;6.待所有平板倒好后(最好静置2h左右),将其放入30 ℃恒温箱中培养12h左右,即可观察有无噬菌斑。
注:所有操作在酒精灯旁进行!噬菌斑效果图培养噬菌体的方法:一. 液体培养法1. 将指定之寄主细菌以液体培养法于适当温度下培养,一般培养16~24小时。
2. 将噬菌体原液100 μl 与寄主细菌悬浮液300 μl均匀混合,静置15分钟使其感染。
3. 将混合液接种至含10 ml新鲜液体培养基的试管中,于适当温度下振荡培养约8~24小时,培养时间依噬菌体之不同而异。
4. 将培养液移入离心管中,以10,000 rpm (5,000 g)离心10分钟,以沉淀寄主细菌。
5. 将上清液移至新管中,以0.22μm孔径之过滤器(filter)去除残余菌体,即得不含寄主细菌之噬菌体原液。

噬菌体侵染细菌的实验方法一、实验前准备1.1 噬菌体的制备噬菌体可以通过多种方法制备,其中最常用的是双层琼脂法。
首先需要选择适合的宿主细菌,并在培养基中培养至对数生长期。
然后将噬菌体接种到宿主细菌中,使其进行感染,待细胞溶解后收集上清液即可。
1.2 细胞培养选择合适的宿主细菌进行培养,通常使用营养丰富的LB培养基或M9最小盐基础培养基等。
二、实验步骤2.1 噬菌体感染实验将目标宿主细菌接种于含有适量培养基的试管中,并在37℃下恒温摇床振荡培养至对数生长期。
将适量噬菌体加入到含有目标细胞的试管中,使其进行感染。
根据不同实验目的和要求,可以调整噬菌体和目标细胞的比例以及感染时间等因素。
2.2 病毒滴度测定病毒滴度测定是评估噬菌体感染效果的重要方法。
将一定量的目标细胞接种于含有适量培养基的96孔板中,并在37℃下恒温摇床振荡培养至对数生长期。
将适量的噬菌体加入到每个孔中,使其进行感染。
根据不同实验目的和要求,可以调整噬菌体和目标细胞的比例以及感染时间等因素。
最后通过滴度计算得出病毒滴度。
2.3 病毒扩增实验病毒扩增实验是将噬菌体在宿主细胞中进行复制和扩增的过程。
首先需要选择合适的宿主细胞,并在含有适量培养基的试管中进行培养。
然后将一定量噬菌体加入到试管中,使其进行感染。
根据不同实验目的和要求,可以调整噬菌体和宿主细胞的比例以及培养时间等因素。
2.4 病毒纯化实验病毒纯化实验是将混合物中的噬菌体分离出来,得到纯净的病毒制品。
首先需要收集感染后的上清液,并将其离心去除细胞碎片和杂质。
然后通过超速离心等方法将病毒分离出来,并进行洗涤和浓缩等步骤,最终得到纯净的病毒制品。
三、实验注意事项3.1 安全操作在进行噬菌体实验时需要注意安全操作,避免病毒泄漏和污染。
应该在生物安全柜中进行实验操作,并采取相应的个人防护措施,如戴手套、口罩等。
3.2 实验设计在进行噬菌体实验时需要合理设计实验方案,根据不同的实验目的和要求选择合适的宿主细菌和噬菌体品系,并根据需要调整感染时间、感染剂量等因素。

噬菌体鉴定遗传物质噬菌体是一种病毒,它可以感染并寄生在细菌体内,通过利用细菌的生物机制来复制自身。
噬菌体鉴定遗传物质的方法是通过分析噬菌体的基因组序列,以确定其种属和亲缘关系。
噬菌体鉴定的首要步骤是提取噬菌体DNA或RNA。
这可以通过不同的方法进行,其中最常用的是酚-氯仿法或商用基因提取试剂盒。
提取的DNA或RNA样品随后需要进行质量检测,以确保样品完整且适合后续分析。
在噬菌体鉴定中,常用的方法是通过测序噬菌体基因组。
测序技术的发展使得高通量测序成为可能,可以同时测序大量的噬菌体样品。
测序后,通过与已知的噬菌体基因组数据进行比对,可以确定噬菌体的种属和亲缘关系。
基于测序数据进行噬菌体鉴定的方法有多种。
一种常用的方法是利用基因组序列的相似性进行比对。
通过使用多序列比对软件,如BLAST或MEGA,可以将噬菌体基因组序列与已知的噬菌体基因组进行比对,从而确定噬菌体的种属和亲缘关系。
另一种方法是利用基因组序列的组成和结构特征进行鉴定。
噬菌体基因组通常由DNA序列和编码基因组的蛋白质序列组成。
通过分析基因组序列的GC含量、编码基因的起始密码子和终止密码子等特征,可以推断噬菌体的种属和亲缘关系。
除了基因组序列,噬菌体鉴定还可以利用其他遗传物质,如噬菌体的RNA或蛋白质。
通过分析噬菌体的转录组或蛋白质组,可以了解噬菌体在感染细菌时的调控机制和功能特征。
这些信息也可以用于噬菌体的鉴定和分类。
噬菌体鉴定的结果对于研究噬菌体的生物学特性、进化关系和应用潜力具有重要意义。
噬菌体鉴定可以帮助科学家了解不同噬菌体的感染机制、宿主范围和抗药性等特征,从而为噬菌体的应用提供理论依据。
噬菌体鉴定遗传物质是通过分析噬菌体的基因组序列、转录组或蛋白质组来确定噬菌体的种属和亲缘关系的方法。
这些信息对于研究噬菌体的生物学特性和应用潜力具有重要意义。
随着测序技术的发展,噬菌体鉴定的方法将变得更加精确和高效。

一、材料准备
1.LB培养基固体,酵母粉0.5%,蛋白胨1%,氯化钠1%,琼脂粉1.5%。
每个待检测样品50ml,
溶解后分装灭菌。
2.2%琼脂,2%琼脂粉加水,根据平板数决定体积。
3.LB液体培养基,酵母粉0.5%,蛋白胨1%,氯化钠1%。
每个样100ml,大肠杆菌100ml。
4.5ml枪头
5.1ml枪头,每个样品1个。
6.培养皿,每个样品2个。
二、操作步骤
1. 将大肠杆菌培养至对数期(OD600nm1-1.5),约12h;
2. 待测菌株也培养至对数期;
3. 取2%的琼脂用水融化,倒10ml至无菌平板(可用移液枪吸取,枪头提前灭菌),等其完全凝固(注意铺平,超净台吹半小时或室温放置1h);
4. 取LB固体培养基融化,置于50℃恒温水浴1h(可以与上部同时进行,节省时间,提前备好水浴);
5. 无菌操作取5ml大肠杆菌菌液及1ml待测菌液,加入恒温水浴的第2瓶融化的固体培养基中,充分混匀;
6. 取上述混合液10ml至上述准备好的平板,保证铺平。
7. 30℃恒温培养12h,观察有无透明圈(噬菌斑),有表示有噬菌体,否则无噬菌体。

噬菌体侵染大肠杆菌实验流程咱开始唠唠噬菌体侵染大肠杆菌的实验流程哈。
一、实验材料准备。
咱得先把噬菌体和大肠杆菌都找齐咯。
这噬菌体就像个小小的病毒特务,专门盯着大肠杆菌呢。
大肠杆菌嘛,就是个可怜的被盯上的小细菌。
你得有合适的培养皿,就像给它们准备好小房子一样,还有各种营养液,好让大肠杆菌能茁壮成长。
噬菌体呢,也得保存好,可不能让它提前“没了活性”。
二、标记噬菌体。
这一步可有意思啦。
咱们要给噬菌体做个小标记,就像给它贴个小标签一样。
可以用放射性同位素来标记呢。
比如说,咱们想标记噬菌体的蛋白质外壳,就用放射性的硫元素;要是想标记噬菌体的DNA呢,就用放射性的磷元素。
为啥这么做呢?这就像是给噬菌体穿上一件会发光的衣服,这样咱们就能追踪它在侵染大肠杆菌的时候,到底是蛋白质进去了,还是DNA进去了。
三、噬菌体侵染大肠杆菌。
现在到了最关键的一步啦。
把标记好的噬菌体和大肠杆菌放在一起,就像是把特务放到了目标身边。
噬菌体可狡猾了,它会紧紧地吸附在大肠杆菌的表面,然后就像个小钻子一样,想办法把自己的东西注入到大肠杆菌里面。
这里面可就有讲究了,到底是它的蛋白质外壳先进去,还是DNA先进去呢?这就是这个实验要探究的重点。
四、搅拌和离心。
这一步听起来就很有动作感。
在噬菌体侵染大肠杆菌一段时间之后,咱们要把它们的混合液搅拌一下。
这就像是把纠缠在一起的两个小生物强行分开一样。
然后再进行离心。
离心就像是一场小小的分离比赛,让比较重的大肠杆菌沉到下面,而噬菌体的外壳呢,就留在上面的溶液里。
通过这一步,咱们就能把噬菌体的外壳和已经被侵染的大肠杆菌分开来研究。
五、检测放射性。
到了见证奇迹的时刻啦。
咱们要检测各个部分的放射性。
如果是标记蛋白质外壳的噬菌体,那要是发现上层溶液有放射性,而沉淀的大肠杆菌没有放射性,那就说明蛋白质外壳没有进入大肠杆菌。
要是标记DNA的噬菌体呢,发现沉淀的大肠杆菌有放射性,那就说明DNA进入到大肠杆菌里面去了。

一、实验目的1. 了解噬菌体的概念、结构及其繁殖过程。
2. 掌握噬菌体侵染细菌的实验原理和方法。
3. 学会使用放射性同位素标记技术追踪噬菌体的侵染过程。
二、实验原理噬菌体是一种专门侵染细菌的病毒,其结构简单,主要由蛋白质外壳和DNA组成。
噬菌体侵染细菌的过程包括吸附、注入、合成、组装、释放等步骤。
本实验通过观察噬菌体侵染细菌的过程,了解噬菌体的繁殖机制。
三、实验材料1. 噬菌体:大肠杆菌噬菌体T22. 大肠杆菌:大肠杆菌菌株3. 放射性同位素:35S(标记噬菌体外壳蛋白)和32P(标记噬菌体DNA)4. 其他试剂:无菌水、NaCl、琼脂糖、酚红指示剂等5. 仪器:离心机、显微镜、紫外分光光度计等四、实验步骤1. 制备噬菌体悬液:将T2噬菌体接种于含有大肠杆菌的液体培养基中,37℃培养2小时,收集噬菌体,用无菌水洗涤沉淀,制成噬菌体悬液。
2. 制备大肠杆菌菌液:将大肠杆菌接种于液体培养基中,37℃培养2小时,收集菌液,用无菌水洗涤沉淀,制成大肠杆菌菌液。
3. 标记噬菌体外壳蛋白:将噬菌体悬液与35S标记的NaCl溶液混合,离心分离,收集上清液,制成35S标记的噬菌体外壳蛋白。
4. 标记噬菌体DNA:将噬菌体悬液与32P标记的NaCl溶液混合,离心分离,收集上清液,制成32P标记的噬菌体DNA。
5. 噬菌体侵染实验:将35S标记的噬菌体外壳蛋白和32P标记的噬菌体DNA分别与大肠杆菌菌液混合,37℃培养30分钟,使噬菌体侵染细菌。
6. 分离噬菌体与细菌:将混合液加入琼脂糖平板,37℃培养过夜,观察噬菌体与细菌的分离情况。
7. 观察实验结果:通过紫外分光光度计检测上清液和沉淀物中的放射性同位素含量,分析噬菌体侵染细菌的过程。
五、实验结果与分析1. 35S标记的噬菌体外壳蛋白主要存在于上清液中,说明噬菌体外壳蛋白在侵染过程中没有进入细菌细胞内。
2. 32P标记的噬菌体DNA主要存在于沉淀物中,说明噬菌体DNA在侵染过程中进入了细菌细胞内。

检测噬菌体的常用方法
哇塞,检测噬菌体的常用方法可真是非常重要呢!那咱就来好好聊聊。
首先呢,双层平板法是比较常用的一种。
先把底层培养基倒在平板上,等它凝固了,再把对数生长期的敏感菌和一定稀释度的噬菌体悬液混合,加到上层培养基里,然后倒在底层培养基上。
等培养好了,就能看到噬菌斑啦!这过程中可得注意咯,培养基的质量得保证好呀,不然会影响结果的哟!还有稀释度要把握好,不然可能看不到或者看不清噬菌斑呢。
再来说说这安全性和稳定性哈。
整个过程只要操作规范,还是很安全的呀,不用担心会有啥大问题。
而且只要严格按照要求来,结果的稳定性也是很不错的哟。
那它都有啥应用场景和优势呢?嘿,这可多啦!在微生物学研究里,能帮助咱了解噬菌体的特性和行为呀。
在发酵工业中,可以检测噬菌体污染,及时采取措施呢。
它的优势就是简单易行、直观有效呀,能快速得到结果呢。
咱举个实际案例哈,之前有个生物实验室,就是用这个方法检测到了噬菌体的存在,及时调整了实验方案,避免了更大的损失呀!你说这效果多明显呀。
所以呀,检测噬菌体的常用方法真的是非常实用和重要的呀!它们就像是我们探索噬菌体世界的得力工具,能让我们更好地了解和利用噬菌体呢!。
大肠埃希菌噬菌体噬斑法的原理大肠埃希菌噬菌体是一种可以感染和破坏大肠埃希菌的噬菌体。
它的发现为处理食物中的致病菌提供了一种新的方法。
噬斑法是一种用于检测和计数大肠埃希菌噬菌体的方法。
它可以
帮助我们了解噬菌体对这些致病菌的控制能力。
噬斑法的原理是利用噬菌体感染大肠埃希菌并破坏它们形成噬菌斑。
噬菌体首先通过尾部上的受体与大肠埃希菌表面的受体结合,然
后注入其基因组进入细菌细胞内。
在细菌细胞内,噬菌体基因组会利
用细菌细胞的代谢机制进行复制和自我组装。
随着噬菌体不断复制和组装,细菌细胞则会逐渐溶解并释放新的
噬菌体。
这种细菌细胞的溶解会形成一个透明的区域,即噬菌斑。
通
过噬菌斑的形成和扩散情况,我们可以判断噬菌体对大肠埃希菌的攻
击效果以及感染性。
噬斑法可以通过在含有大肠埃希菌的琼脂平板上滴加噬菌体溶液
来进行。
滴加后,在适当的条件下,噬菌体会感染大肠埃希菌并产生
噬菌斑。
通过放大和观察这些噬菌斑,我们可以计数并评估噬菌体对
大肠埃希菌的控制能力。
噬斑法在食品和药品领域具有广泛的应用价值。
通过使用噬斑法,我们可以快速、准确地检测食品中的大肠埃希菌数量,并评估食品安
全性。
此外,噬斑法还可以用于筛选和评估新型噬菌体的效果,为抗生素替代品的研发提供指导意义。
总之,大肠埃希菌噬菌体和噬斑法为解决食品安全问题提供了新的途径。
通过了解其原理和应用,我们可以更好地利用噬菌体来控制和预防大肠埃希菌感染,保障人们的健康和食品安全。
实验名称:噬菌体侵染细菌实验实验目的:通过模拟赫尔希和蔡斯的经典实验,探究噬菌体在侵染细菌过程中的DNA与蛋白质的分离与作用,验证DNA是遗传物质的假设。
实验时间:2023年10月15日实验地点:实验室实验材料:- 大肠杆菌菌株- T2噬菌体- 32P标记的T2噬菌体- 35S标记的T2噬菌体- 未标记的T2噬菌体- 15N标记的T2噬菌体- 放射性同位素计数器- 离心机- 培养皿- 试管- 滤纸- 移液器实验方法:1. 标记噬菌体:- 使用32P标记的T2噬菌体,标记其DNA。
- 使用35S标记的T2噬菌体,标记其蛋白质外壳。
- 使用15N标记的T2噬菌体,同时标记其DNA和蛋白质外壳。
2. 噬菌体侵染细菌:- 将标记过的噬菌体与大肠杆菌混合培养。
- 在一定时间后,离心混合物,分离出噬菌体的蛋白质外壳和含有噬菌体DNA 的细菌。
3. 检测放射性:- 使用放射性同位素计数器检测上清液和沉淀物中的放射性物质。
- 分析放射性物质在沉淀物和上清液中的分布情况。
实验结果:1. 32P标记的噬菌体侵染未标记的细菌:- 检测结果显示,放射性物质主要集中在沉淀物中。
- 这表明32P标记的噬菌体DNA进入了细菌细胞。
2. 15N标记的噬菌体侵染未标记的细菌:- 检测结果显示,放射性物质主要集中在沉淀物和上清液中。
- 这表明15N标记的噬菌体DNA和蛋白质外壳都进入了细菌细胞。
3. 未标记的噬菌体侵染35S标记的细菌:- 检测结果显示,放射性物质主要集中在沉淀物中。
- 这表明未标记的噬菌体DNA进入了细菌细胞,而35S标记的蛋白质外壳留在了上清液中。
实验结论:1. DNA是噬菌体侵染细菌过程中的遗传物质。
2. 噬菌体的DNA进入细菌细胞,指导细菌合成新的噬菌体。
3. 噬菌体的蛋白质外壳留在细菌细胞外,不参与遗传物质的传递。
实验讨论:1. 本实验通过放射性同位素标记法,成功验证了DNA是噬菌体遗传物质的观点。
2. 实验结果与赫尔希和蔡斯的经典实验结果一致,证明了DNA在遗传信息传递中的重要作用。
噬菌体效价的测定方法噬菌体效价的测定方法1. 引言噬菌体效价的测定方法是研究噬菌体杀菌能力的重要手段。
本文将详细介绍几种常用的噬菌体效价测定方法。
2. 噬菌体效价测定方法斑点法斑点法是最常用的测定噬菌体效价的方法之一。
具体步骤如下:1.准备一系列浓度递减的噬菌体溶液。
2.在琼脂平板上均匀涂敷被测细菌悬浮液。
3.取一定体积的已知浓度的噬菌体溶液滴在已涂敷的平板上,静置一段时间。
4.观察液滴周围是否出现菌落溶解区,根据出现溶解区的数量和大小,推断噬菌体的效价。
流式细胞术法流式细胞术法是一种快速测定噬菌体效价的方法,适合大规模实验。
具体步骤如下:1.准备一系列浓度递减的噬菌体溶液。
2.将被测细菌悬浮液加入流式细胞仪中,通过光散射和荧光信号检测细菌的状态。
3.依据细菌的状态判断噬菌体的效价。
确定感染能力的法确定感染能力的法是一种精确测定噬菌体效价的方法,可以测定细菌在固定时间内被噬菌体感染的能力。
具体步骤如下:1.准备一系列浓度递减的噬菌体溶液。
2.将细菌与噬菌体溶液接触一定时间后,离心沉淀细菌。
3.通过对沉淀细菌进行计数或直接培养识别,确定细菌被感染的数量。
4.根据感染数量和噬菌体浓度计算噬菌体的效价。
3. 结论本文介绍了斑点法、流式细胞术法和确定感染能力的法三种常用的噬菌体效价测定方法。
这些方法各有优缺点,研究者可以根据实际需求选择合适的方法进行噬菌体效价的测定。
4. 斑点法的优点和缺点优点•斑点法操作简单,易于掌握。
•可以同时测定多个噬菌体效价,提高效率。
•结果直观,通过观察菌落溶解区可以准确判断噬菌体效价。
缺点•斑点法需要较长的时间来观察菌落溶解区的形成,耗时较长。
•结果的定量分析相对不准确,只能通过观察溶解区数量和大小来推测效价。
•受到环境因素的影响较大,如温度、湿度等。
5. 流式细胞术法的优点和缺点优点•流式细胞术法速度快,可对大量样本进行高通量分析。
•结果定量准确,可以精确地获得细菌的状态信息。
细菌噬菌体应该如何检测噬菌体是一类专性寄生于细菌和放线菌等微生物的病毒,其个体形态极为微小,用常规微生物计数法无法测得其数量。
当烈性噬菌体侵染细菌后会迅速引发灵敏细菌裂解,释放出大量子代噬菌体,然后它们再扩散和侵染周围细胞,最终使含有灵敏菌的悬液由混浊慢慢变清,或在含有灵敏细菌的平板上显现肉眼可见的空斑──噬菌斑。
了解噬菌体的特性,快速检查、分离,并进行效价测定,对在生产和科研工作中避免噬菌体的污染具有重要作用。
检样能够是发酵液、空气、污水、土壤等(至于无法采样而需检查的对象,能够用无菌水浸湿的棉花涂拭表面作为检查样品)。
为了易于分离可先经增殖培育,使样品中的噬菌体数量增加。
采纳微生物测定法进行噬菌体检测,约需12h左右,因此不能及时判定是不是有噬菌体污染。
通过快速检测可大致确信是不是有噬菌体污染,以采取必要的防治方法。
根据正常发酵(培育)液离心后菌体沉淀,上清液蛋白含量很少,加热后仍然清亮;而侵染有噬菌体的发酵(培育)液经离心后其上清液中因含有自裂解菌中逸出的活性蛋白,加热后发生蛋白质变性,因此在光线照射下显现丁达尔效应而不清亮。
此法简单、快速,对发酵液污染噬菌体的判定亦较准确。
但不适于溶源性细菌及温合噬菌体的诊断,对侵染噬菌体较少的一级种子培育液也往往不适用。
噬菌体的效价即1mL样品中所含侵染性噬菌体的粒子数。
效价的测定一样采纳双层琼脂平板法。
由于在含有特异宿主细菌的琼脂平板上,一样一个噬菌体产生一个噬菌斑,故可依照必然体积的噬菌体培育液所显现的噬菌斑数,计算出噬菌体的效价。
此法所形成的噬菌斑的形态、大小较一致,且清楚度高,故计数比较准确,因此被普遍应用。
检测材料1.菌种灵敏指示菌(大肠杆菌)、大肠杆菌噬菌体(从阴沟或粪池污水中分离)2.培育基两倍肉膏蛋白胨培育液,上层肉膏蛋白胨半固体琼脂培育基(含琼脂%,试管分装,每管mL),基层肉膏蛋白胨固体琼脂培育基(含琼脂2%),1%蛋白胨水培育基。